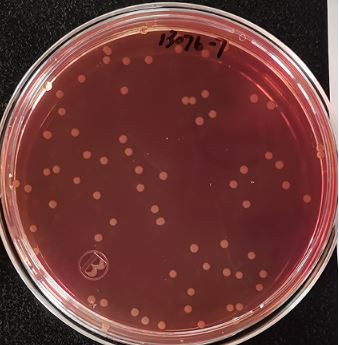
VRBA內(nèi)的紅色小菌落，有可能是沙門氏菌？

最近,檢測圈的一個傳聞引起檢測大神們的瘋狂討論—沙門氏菌在VRBA內的菌落是紅色的!從原理上來說,這是不可能的!從傳聞來看,又像是真實存在的!為了破解這個謎題,我們做了相關的驗證試驗。
首先我們要了解一下VRBA培養基的成分及沙門氏菌的生化特性。
VRBA及沙門氏菌生化原理剖析
先來看VRBA培養基的組成成分(圖1)及原理:

圖1 VRBA的組成成分
VRBA培養基中含有乳糖和中性紅。大腸菌群可發酵乳糖產酸,引起pH值的變化,中性紅作為酸堿指示劑使菌落變紅;酸與膽鹽結合形成膽酸鹽沉淀,故菌落周圍會有紅色的膽酸鹽沉淀環。
所以大腸菌群菌落變紅是由于發酵乳糖產酸導致的!
了解了菌落變紅的原理,我們再來看一下沙門氏菌的生化特性:

圖2 三糖鐵試驗結果
從三糖鐵的試驗結果(圖2)看,沙門氏菌不能利用乳糖,只能利用葡萄糖,而VRBA 的成分中并沒有葡萄糖!從原理上分析,沙門氏菌在VRBA上不會形成紅色菌落。所以傳聞會是真的么?
試驗驗證
首先,我們采用涂布法,在VRBA表面接種沙門氏菌。結果發現,沙門氏菌在VRBA表面呈現大的無色菌落(圖3)。這符合沙門氏菌的特征,沙門氏菌一般不發酵乳糖,但在有氧條件下分解蛋白胨產堿,所以在VRBA表面形成大的無色菌落。
燃鵝,我們繼續采用傾注法,在VRBA內部接種沙門氏菌。結果發現,沙門氏菌在VRBA內部形成的小小菌落(圖4)竟然是紅色的!紅色的!!紅色的!!!
這是為什么捏?我們試驗所用腸炎沙門氏菌不發酵乳糖啊?難道VRBA培養基中可能存在少量的沙門氏菌可利用的糖類,長在內部的沙門氏菌利用該糖產酸,菌落周圍培養基pH值變化,使菌落呈現紅色?
為此我們做了原料的排查試驗,采用去掉酵母浸粉成分的VRBA,以傾注法接種沙門氏菌。結果發現,沙門氏菌在VRBA內部形成小菌落是無色的了(圖5黃圈里的菌落)。
圖3 腸炎沙門氏菌ATCC13076涂布接種

圖4 腸炎沙門氏菌ATCC13076傾注接種

圖5 腸炎沙門氏菌ATCC13076傾注接種去掉酵母粉后的VRBA
酵母浸粉含糖是正常的么?
為此我們查閱了酵母提取物中所含的營養成分,有資料顯示,酵母提取物含有碳水化合物【1】,而碳水化合物主要來源于酵母菌的細胞壁和細胞膜【2】,在酵母提取物生產的過程中,先經過細胞酶解自溶【2】,細胞溶解后,碳水化合物就存在于酵母提取物中。英國食品標準局公布的酵母提取物(調味品類)的營養成分表中,每100g酵母提取物中含糖1.6g。推測酵母提取物本身就含有一定的糖類。由于酵母浸粉中本身就含有一定糖類,沙門氏菌利用其中的糖類產生酸,從而在VRBA內形成了紅色小菌落。 那么,其他品牌VRBA的酵母浸粉是否含糖類呢?為此我們又進行了比對試驗,用傾注接種ATCC14028鼠傷寒沙門氏菌。A-E代表不同品牌的培養基,其中A為陸橋,E為某進口品牌。結果發現沙門氏菌在A、C和E三個品牌VRBA內部都會形成小小的紅色菌落,而在B和D品牌VRBA內部卻形成了大的紅色菌落,有些菌落周圍還會有膽酸鹽沉淀(圖6),與大腸菌群典型菌落相似。至此,所有的疑問都已解開。原來沙門氏菌真的會在VRBA內部形成紅色菌落,但在大部分品牌VRBA上沙門氏菌菌落很小,與典型大腸菌群還是比較好區分的,且BGLB驗證時很容易排除。
參考文獻:
1、Difco&BBL Mannal: Second Edition【M】United States of America, 2009
2、張曉桐等,酵母提取物提取工藝及應用的研究進展【J】中國調味品,2019,002(044):160-163